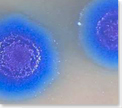
Genome Transplantation Method
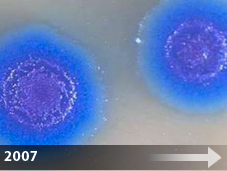
2007

Genesis of SGI – Our Timeline
In 2005 when Dr. J. Craig Venter and his team founded Synthetic Genomics Inc., they did so based on the new tools, techniques and knowledge they had developed from decades of their pioneering genomics research. They believed that there were real commercial applications for some of the breakthroughs they had been making in the new field of synthetic genomics. They also recognized that some of the first potential applications, including next generation biofuels and chemicals, were of critical importance for the long-term health of the planet and its people.
Background
In the last two decades the field of genomics has undergone a rapid transformation, with scientific discoveries coming at an ever-dazzling pace. These breakthroughs were made possible by advances in underlying enabling technologies such as high-throughput DNA sequencing, high-performance computing and bioinformatics. These advances, many of which are directly attributable to the innovation of Dr. Venter and his teams, have enabled researchers to readily sequence and analyze the genetic code. So far the genomes of more than a thousand organisms and millions of genes have been discovered, with many available in public databases.
Now, Drs. Venter and Smith and their teams have progressed from simply reading the genetic code to writing it. This ability led to their development of the new field of synthetic genomics in which genes and whole chromosomes can be designed, synthesized and assembled in the lab. They have ignited a new revolution in biological science, which holds the promise to transform many industries. Genes are now the design components of the future and the SGI team, as the leaders of this field, are developing and applying these next-generation genomic tools toward large-scale commercial applications. Here is a short history of our young and dynamic company, our milestones, and the science upon which it was founded.
1990’s
 After sequencing the Mycoplasm genitalium genome, Dr. Venter and colleagues at his not-for-profit research organization, The Institute for Genomic Research (TIGR) began work on the minimal genome project. This research, focused on understanding the minimal genetic components necessary to sustain life, started with M. genitalium because it is a bacterium with the smallest genome known that can be grown in pure culture. This work was published in the journal Science in 1995.
After sequencing the Mycoplasm genitalium genome, Dr. Venter and colleagues at his not-for-profit research organization, The Institute for Genomic Research (TIGR) began work on the minimal genome project. This research, focused on understanding the minimal genetic components necessary to sustain life, started with M. genitalium because it is a bacterium with the smallest genome known that can be grown in pure culture. This work was published in the journal Science in 1995.
2003
 As part of the effort to understand the environment and the unseen organism that live in our soils and oceans, Dr. Venter and the team at his not-for-profit, J. Craig Venter Institute, launched a global ocean sampling effort, the Sorcerer II Expedition. The team first started with a test project in the Sargasso Sea, because it was thought to be a desert devoid of microbial life. Instead, what the team discovered was more than 1.3 million new genes and an estimated 1,800 new species. These results were published in the journal Science in 2004.
As part of the effort to understand the environment and the unseen organism that live in our soils and oceans, Dr. Venter and the team at his not-for-profit, J. Craig Venter Institute, launched a global ocean sampling effort, the Sorcerer II Expedition. The team first started with a test project in the Sargasso Sea, because it was thought to be a desert devoid of microbial life. Instead, what the team discovered was more than 1.3 million new genes and an estimated 1,800 new species. These results were published in the journal Science in 2004.
After this initial success, Dr. Venter embarked on a two-year circumnavigation of the globe covering over 20,000 nautical miles. The Sorcerer II sailed across the Atlantic, Pacific and Indian Oceans. Water samples of 200-400 liters were collected every 200 miles from the ocean. The team also sampled soil from some of the unique environments they encountered.
November 2003
 Drs. Venter, Smith and Hutchison (along with JCVI’s Cynthia Andrews-Pfannkoch) made the first significant strides in the development of a synthetic genome by assembling the 5,386 base pair genome of bacteriophage ΦX174 (PhiX). They did so using short, single strands of synthetically produced, commercially available DNA (known as oligonucleotides) and using an adaptation of the polymerase chain reaction (PCR), known as polymerase cycle assembly (PCA), to build the phi X genome. The team produced the synthetic phi X in just 14 days.
Drs. Venter, Smith and Hutchison (along with JCVI’s Cynthia Andrews-Pfannkoch) made the first significant strides in the development of a synthetic genome by assembling the 5,386 base pair genome of bacteriophage ΦX174 (PhiX). They did so using short, single strands of synthetically produced, commercially available DNA (known as oligonucleotides) and using an adaptation of the polymerase chain reaction (PCR), known as polymerase cycle assembly (PCA), to build the phi X genome. The team produced the synthetic phi X in just 14 days.
2005
 The major scientific breakthrough in synthesizing phi X was a proof of concept that gave the team assurance of the potential of this technology and encouragement to pursue this work in a commercial setting.
The major scientific breakthrough in synthesizing phi X was a proof of concept that gave the team assurance of the potential of this technology and encouragement to pursue this work in a commercial setting.
SGI was then founded in the spring of 2005 by J. Craig Venter, Ph.D, Nobel Laureate Hamilton O. Smith, M.D., Juan Enriquez and David Kiernan, M.D., J.D.
February 2006
 SGI appointed Aristides A.N. Patrinos, Ph.D., former director of the Office of Biological and Environmental Research at the U.S. Department of Energy’s Office of Science, as president and established a Washington DC area presence.
SGI appointed Aristides A.N. Patrinos, Ph.D., former director of the Office of Biological and Environmental Research at the U.S. Department of Energy’s Office of Science, as president and established a Washington DC area presence.
The company raised its Series A round of financing from Draper Fisher Juvetson, Meteor Group, Biotechonomy LLC and Plenus, S.A. de C.V. and started a sponsored research agreement with JCVI.
2006
 SGI opened its La Jolla, CA facilities and established research teams in the area of environmental genomics, microbiology, bioinformatics, plant genomics and genome engineering.
SGI opened its La Jolla, CA facilities and established research teams in the area of environmental genomics, microbiology, bioinformatics, plant genomics and genome engineering.
March 2007
 The results from the first phases of the circumnavigation of the Sorcerer II Expedition were published in a special issue of PLOS Biology. The data represent the largest metagenomic dataset ever put into the public domain with more than 7.7 million sequences or 6.3 billion base pairs of DNA. More than six million new genes, thousands of new protein families and an incredible degree of microbial diversity were discovered. Analysis continues on the samples from the remainder of the expedition with estimates of hundreds of thousands to millions more genes to be uncovered. Through this project Dr. Venter and his team believe that genes have the potential to be the design components of the future. These discoveries will revolutionize the future of SGI’s technologies.
The results from the first phases of the circumnavigation of the Sorcerer II Expedition were published in a special issue of PLOS Biology. The data represent the largest metagenomic dataset ever put into the public domain with more than 7.7 million sequences or 6.3 billion base pairs of DNA. More than six million new genes, thousands of new protein families and an incredible degree of microbial diversity were discovered. Analysis continues on the samples from the remainder of the expedition with estimates of hundreds of thousands to millions more genes to be uncovered. Through this project Dr. Venter and his team believe that genes have the potential to be the design components of the future. These discoveries will revolutionize the future of SGI’s technologies.
June 2007
 SGI formed a collaboration with BP to develop and commercialize microbial-enhanced solutions to increase the conversion and recovery of subsurface hydrocarbons.
SGI formed a collaboration with BP to develop and commercialize microbial-enhanced solutions to increase the conversion and recovery of subsurface hydrocarbons.
June 2007
JCVI researchers led by Carole Lartigue, Ph.D., published in Science, the methods and techniques used to change one bacterial species, Mycoplasma capricolum, into another, Mycoplasma mycoides. Genome transplantation was a key proof of concept in the field of synthetic genomics as it is a key mechanism by which chemically synthesized chromosomes can be activated into viable living cells. This research was sponsored by SGI.
JCVI researchers led by Carole Lartigue, Ph.D., published in Science, the methods and techniques used to change one bacterial species, Mycoplasma capricolum, into another, Mycoplasma mycoides. Genome transplantation was a key proof of concept in the field of synthetic genomics as it is a key mechanism by which chemically synthesized chromosomes can be activated into viable living cells. This research was sponsored by SGI.
July 2007
 SGI formed a collaboration with ACGT Sdn Bhd to develop more high-yielding and disease-resistant plant feedstocks. The partnership entails sequencing oil seed plants such as oil palm and jatropha.
SGI formed a collaboration with ACGT Sdn Bhd to develop more high-yielding and disease-resistant plant feedstocks. The partnership entails sequencing oil seed plants such as oil palm and jatropha.
SGI closed its Series B round of financing with BP and ACGT.
January 2008
 JCVI researchers, sponsored by SGI, completed proof-of-concept on the second successful step in the journey to create a cell using synthetic DNA. JCVI’s Gibson et al published the synthetic M. genitalium genome research in Science.
JCVI researchers, sponsored by SGI, completed proof-of-concept on the second successful step in the journey to create a cell using synthetic DNA. JCVI’s Gibson et al published the synthetic M. genitalium genome research in Science.
May 2008
 SGI and ACGT completed the first draft assembly and annotation of the oil palm genome. The organizations also announced making progress in sequencing and analyzing the jatropha genome.
SGI and ACGT completed the first draft assembly and annotation of the oil palm genome. The organizations also announced making progress in sequencing and analyzing the jatropha genome.
December 2008
 The JCVI team, sponsored by SGI, published a paper in the Proceedings of the National Academy of Sciences describing a significant advance in genome assembly in which they created the synthetic M. genitalium genome from 25 overlapping fragments in a one-step assembly using recombination in yeast. The team is still working on experiments to install a fully synthetic bacterial chromosome into a recipient cell and “boot up” this synthetic chromosome.
The JCVI team, sponsored by SGI, published a paper in the Proceedings of the National Academy of Sciences describing a significant advance in genome assembly in which they created the synthetic M. genitalium genome from 25 overlapping fragments in a one-step assembly using recombination in yeast. The team is still working on experiments to install a fully synthetic bacterial chromosome into a recipient cell and “boot up” this synthetic chromosome.
Investors
The company’s largest investors include: BP plc; Biotechonomy LLC; Draper Fisher Jurvetson; Plenus, S.A. de C.V.; ACGT Sdn Bhd; and Meteor Group.
Click here to learn more about our investors and
investing in our company

Jatropha genome completed.
Jatropha genome completed.